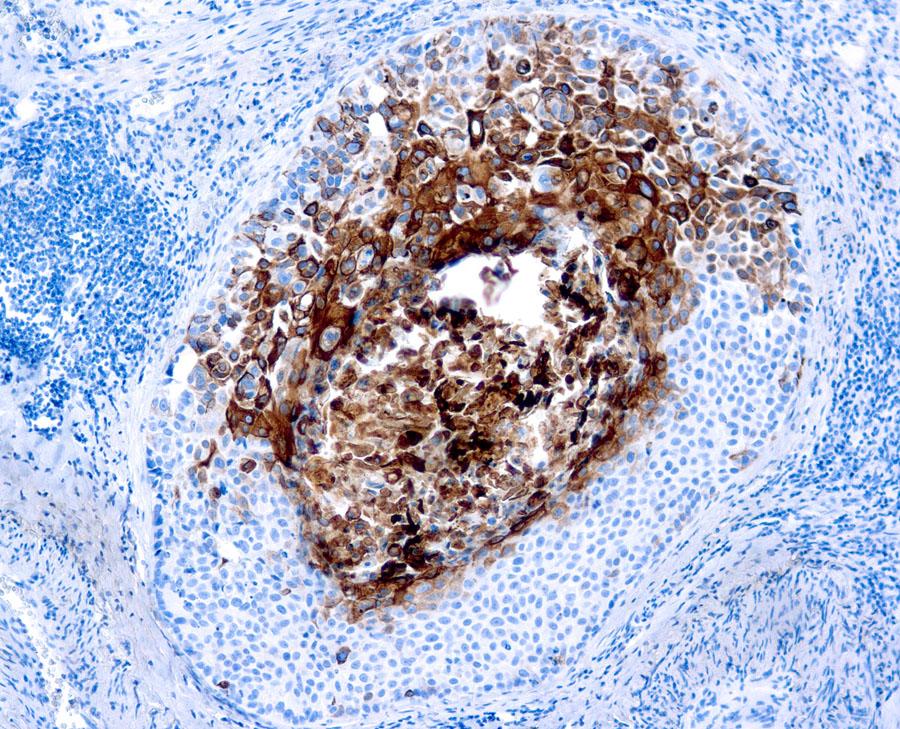

Mouse Monoclonal Antibody to Cytokeratin 17(Clone: E3)(Discontinued)
Figure 1 : Formalin fixed paraffin embedded human skin stained with Cytokeratin 17 antibody ( 10-11547).
Roll over image to zoom in

Shipping Info:
For estimated delivery dates, please contact us at [email protected]
Format : | T.C. Sup. |
Amount : | 0.5 ml |
Isotype : | Mouse IgG2b, Kappa |
Content : | This antibody is supplied as tissue culture supernatant containing sodium azide as preservative. |
Storage condition : | Store at 2-8°C. |
This antibody is specific to 46 kDa cytokeratin protein designated cytokeratin 17. It reacts with basal cells in complex epithelia and reacts strongly with squamous cell carcinomas.
IHC : 1:25-1:50
For Research Use Only. Not for use in diagnostic/therapeutics procedures.
Subcellular location: | Cytoplasm |
Post transnational modification: | Phosphorylation at Ser-44 occurs in a growth- and stress-dependent fashion in skin keratinocytes, it has no effect on filament organization. |
Tissue Specificity: | Expressed in the outer root sheath and medulla region of hair follicle specifically from eyebrow and beard, digital pulp, nail matrix and nail bed epithelium, mucosal stratified squamous epithelia and in basal cells of oral epithelium, palmoplantar epidermis and sweat and mammary glands. Also expressed in myoepithelium of prostate, basal layer of urinary bladder, cambial cells of sebaceous gland and in exocervix (at protein level). |
BioGrid: | 110070. 42 interactions. |
There are currently no product reviews
|